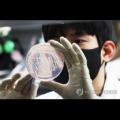

지난 뉴스

한밤중 아프면 어쩌죠… 공공심야약국 10년째 ‘깜깜’
공공보건의료를 강화하기 위해 지난 2015년 10월부터 운영돼 왔다. 올해 6월 기준 도내 운영 약국은 총 80곳으로 이 중 66곳이 경기 남부권, 14곳이 경기 북부권에 위치해 있다. 하지만 시·군 간 운영 약국 수의 격차가 심하다. 시·군별로 살펴보면 성남시가 8곳으로 가장 많았고, 이어 화성시 7곳, 수원시와 용인시...
경기일보 | 기사작성일 : 2025-06-15

강원·경북, 노인에 병원 등 의료 접근성 나빠…"앞으로 악화일로"
지역은 의료서비스 접근성이 양호하게 나타난 반면 강원과 경북은 접근성이 대체로 낮게 확인됐다. 연구진이 2027년, 2032년, 2037년, 2042년 65세 이상 노인 수까지 추계하자 접근성 지수 하위 시군구 1위는 4차례 모두 경기 수원시 장안구였다. 부산 영도구가 2027년, 2032년 2차례 2위에 올랐고 2037년 3위, 2042년...
뉴스1 | 기사작성일 : 2025-06-15
[로컬라이프] 수원시보건소, 2025년 제2차 수원시 아동 의료지원 운영위원회 개최
사진/수원시보건소가 수원시 아동 의료지원 운영위원회 회의를 열고 있다.(사진제공=수원시) 수원시보건소는 12일 권선구보건소에서 '수원시 아동 의료지원 운영...
로컬라이프 | 기사작성일 : 2025-06-15

수원시, 치료보다 예방 세류3동 ‘모기 없는 마을’ 만든다
경기 수원시 권선구보건소가 지난 9일 세류3동 행정복지센터에서 '모기 없는 마을 만들기' 사업으로 감염병 예방 홍보·교육을 진행했다. 세류3동 통장 30여 명을 대상...
MSN | 기사작성일 : 2025-06-14

알키메이커 주식회사, 수원시 영통구 보건소 '스마트 워킹' 운동교실에...
알키메이커 관계자는 "보행분석 기술을 활용해 지역주민의 건강한 삶에 기여할 수 있어 매우 뜻깊다"며, "앞으로도 공공기관, 의료전문가와의 협력을 통해 보다 체계적이고 효과적인 헬스케어 활동을 더욱 체계적으로 전개해 나갈 계획"이라고 밝혔다. 한편, 알키메이커 주식회사는 경기도 사회적경제원이...
이투뉴스 | 기사작성일 : 2025-06-13

수원시보건소, 2025년 제2차 수원시 아동 의료지원 운영위원회 개최
[서프라이즈뉴스] 수원시보건소는 12일 권선구보건소에서 '수원시 아동 의료지원 운영위원회' 회의를 개최했다. '수원시 아동담당의 의료지원에 관한 조례'에 근거해...
서프라이즈뉴스 | 기사작성일 : 2025-06-13
부안서도 '풀무원 빵' 집단식중독⋯살모넬라 감염 확산
19일 경기도 수원시 권선구 경기도보건환경연구원에서 연구원들이 식중독균 배양분리작업을 시연하고 있다. 연합뉴스 제공 충북에서 급식에 제공된... 만약 해당 제품을 섭취해 설사, 구토 등 증상이 발생하며 바로 의료기관의 진료를 받아야 하고, 동일 기관에서 유증상자가 2명 이상인 경우 보건소로...
전북일보 | 기사작성일 : 2025-06-13

수원시보건소, 의료사각지대 아동 치료비 지원 등 심의
‘수원시 아동 의료지원 운영위원회’ 회의 개최 경기 수원시보건소는 12일 권선구보건소에서 ‘수원시 아동 의료지원 운영위원회’ 회의를 개최했다. ‘수원시 아동담당의 의료지원에 관한 조례’에 근거해 설치된 ‘수원시 아동 의료지원 운영위원회’는 수원시 아동 담당의 의료지원 사업을 위한 추진...
NSP통신 | 기사작성일 : 2025-06-13

[패트롤] 광명시-김포시-안양시-안산시-의왕시
기본사회 분야에선 저출생-고령화 대응을 위한 통합 돌봄 확대와 공공의료 인프라 강화 등 생애주기별 복지 체계 마련이 중점과제로 논의됐다. 이와... 작년에 이어 올해도 수상하며 안양시는 경기도 규제혁신 우수사례 경진대회에서 도내 지자체 중 가장 많은 수상(총 6회)을 기록했다. 안양시는 10일 수원시...
에너지경제 | 기사작성일 : 2025-06-12

[수원소식]우만2동·동부파출소, 특이민원 대응 모의훈련 등
경기 수원시 우만2동 행정복지센터는 11일 동부파출소와 함께 행정복지센터 민원실에서 민원인의 폭언·폭행 상황을 가정한 특이민원 대응 경찰 합동... ◇건보 인천경기본부, 신규 노인요양시설 안전 지원사업 추진 국민건강보험공단 인천경기지역본부는 대한물리치료사협회 경기도회, 경기도...
뉴시스 | 기사작성일 : 2025-06-11

수원시, 치료보다 예방 세류3동 ‘모기 없는 마을’ 만든다
경기 수원시 권선구보건소가 지난 9일 세류3동 행정복지센터에서 ‘모기 없는 마을 만들기’ 사업으로 감염병 예방 홍보·교육을 진행했다. 세류3동 통장 30여 명을 대상으로 모기·진드기 등 해충 매개 감염병 예방의 중요성을 강조하고 방제 협조를 요청했다. 세류3동은 구도심 특성상 정화조와 노후주택이...
NSP통신 | 기사작성일 : 2025-06-11

수원시 영통구 매탄2동, 이안한방병원과 의료서비스 지원을 위한 업무 협약 체결
정치/사회,교육/문화, 입시정보, 체험활동,베트남소식,종합, 연예/스포츠 등 기사제공.
비전21뉴스 | 기사작성일 : 2025-06-11

[대전시 소식] 대전시, 소상공인 인건비 지원 문턱 확 낮췄다
한편, 대전시는 지난해에도 경기도 수원시에서 열린 제50회 전국 품질분임조 경진대회에서 금상 8개, 은상 3개, 동상 3개 등 총 14개 팀 수상이라는... 또한, 야외 활동 후 2주 이내에 38도 이상의 고열, 구토, 설사 등 증상이 나타날 경우 즉시 의료기관을 방문해 진료를 받아야 한다. 최근 대전에서는 실제로...
프라임경제 | 기사작성일 : 2025-06-11

[Who Is ?] 안재현 SK케미칼 대표이사 사장
DDS는 충남 논산에 있는 의료폐기물 소각 기업이다. △회사이름 변경으로 환경기업 탈바꿈 안재현이 SK건설 대표로 있을 시절에 SK건설은... ◆ 비전과 과제 안재현 SK케미칼 대표이사 사장(오른쪽)이 2025년 4월24일 '수원 지관서가'의 개관식에 참석한 뒤 이재준 수원시특례시장과 함께 기념사진을 찍고...
비즈니스포스트 | 기사작성일 : 2025-06-11

[인터뷰] 이찬용 수원시의회 도시미래위원장 "사람 위한 스마트도시 성...
"수원시도 이미 AI 교육과 국책 사업에 적극 참여하고 있지만 중요한 건 '시민 중심의 구현'이다. 사람을 위한 스마트 도시로 성장할 수 있도록 정책적... 단순히 하나의 의료시설이 아니라 서수원 주민들의 의료서비스를 책임지는 믿을 수 있는 공공의료거점이 될 수 있도록 시의회도 끝까지 책임감을 갖고...
천지일보 | 기사작성일 : 2025-06-11
상기 뉴스 정보는 지능형 빅데이터분석에 의해 약 99%의 정확도로 제공됩니다.
 1.0℃
1.0℃
